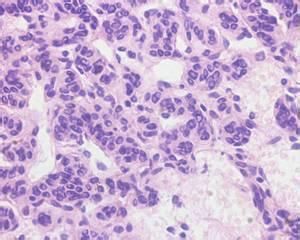
APUD

定義
APUD細胞系統即瀰漫性神經內分泌系統(disseminative neuroendocrine system),是指廣泛分布在全身各部位的一些內分泌細胞和細胞群,這些細胞內含有胺或具有攝取胺的前體,進行脫羧反應的能力[(Amine (胺),pre- cursor (前體),Uptake(攝取),Decarboxylation(脫羧)],把具有這種特性(或能力)的所有細胞統稱為APUD細胞系統。
APUD
APUD簡介
由於APUD細胞銀染色呈陽性,又稱為嗜銀細胞;目前普遍認為APUD細胞來自神經外胚層的神經嵴細胞或內胚層細胞(即神經上皮編碼的內胚層細胞),且均有內分泌功能,故有人又稱之為神經-內分泌細胞。
APUD細胞的分布:遍布全身各部位,以腦和胃腸道最多,肺、胰、膽道、咽喉、鼻、涎腺,泌尿、生殖道以及皮膚等部位均有很多的神經內分泌細胞存在。如胃腸道的親銀或嗜銀細胞、甲狀腺C細胞、胰島細胞、垂體的ACTH細胞、腎上腺嗜鉻細胞、頸動脈體I型細胞、肺的嗜銀細胞和泌尿生殖道的一些透明細胞等。
這一概念是由Pearse於1966年根據產生肽類和腎上腺素類細胞具有這一共同的細胞化學特徵而提出來的。已發現40餘種之多:在中樞存在於下丘腦-垂體軸和松果體,在周圍存在於胃、腸、胰、呼吸系統、泌尿生殖系統、甲狀腺、甲狀旁腺及腎上腺髓質。如甲狀腺有分泌降鈣素的C細胞,胃有分泌胃泌素的G細胞、胰島有分泌胰島素的B細胞及分泌高血糖素的A細胞、十二指腸有分泌腸促胰肽(secretin)的S細胞和分泌胃性抑制肽(gastric inhibitory peptide)的細胞等等。
APUD瘤:APUD細胞發生的腫瘤可以統稱之為APUD瘤。目前由於免疫組化和免疫細胞化學技術的進步,已能加以鑑別並起用各自的名稱,如ACTH瘤、胃泌素瘤、血管活性腸肽瘤(VIPoma)等。
DNES(diffuse neuroendocrine system):即彌散神經內分泌系統。近年來隨著APUD細胞類型和分布的不斷擴展,發現神經系統內的許多神經元也合成和分泌與APUD細胞相同的膠和(或)肽類物質。因此學者們提出,將這些具有分泌功能的神經元(稱分泌性神經元,secretory neuron)和APUD細胞統稱為彌散神經內分泌系統(diffuse neuroendocrine system,DNES)。DNES是在APUD基礎上進一步發展和擴充的,它把神經系統和內分泌系統統一起來構成一個整體,共同調節機體生理活動的平衡。
DNES分中樞和周圍兩大部分。中樞部分包括下丘腦-垂體軸的細胞和松果體細胞。周圍部分包括分布在胃腸胰、呼吸道、泌尿生殖管道內的內分泌細胞,以及甲狀腺的濾泡旁細胞、甲狀旁腺細胞、腎上腺髓質細胞;和部分心肌細胞與平滑肌細胞等。這些細胞產生的胺類物質,如:兒茶酚胺、多巴胺、5-羥色胺、去甲腎上腺素、褪黑激素、組胺等;肽類物質種類很多,如:加壓素和催產素,腺垂體的前述各種激素,以及諸多內分泌細胞分泌的胃泌素,P物質、腦啡肽、心鈉素等。
例如:甲狀腺有分泌降鈣素的C細胞,胃有分泌胃泌素的G細胞,胰島有分泌胰島素的B細胞及分泌高血糖素的A細胞,十二指腸有分泌腸促胰肽(secretin)的S細胞和分泌胃性抑制肽(gastric inhibitory peptide)的細胞等等。
